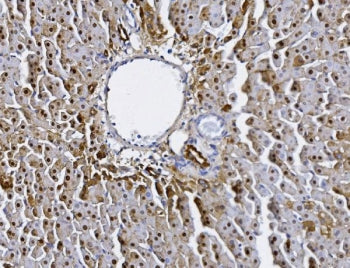

1
/
of
1
NSJ Bioreagents
SKU:RQ6559
Alanine aminotransferase 1 Antibody
Alanine aminotransferase 1 Antibody
Regular price
$439.00 USD
Regular price
Sale price
$439.00 USD
Unit price
/
per
Shipping calculated at checkout.
Couldn't load pickup availability
This gene encodes cytosolic alanine aminotransaminase 1 (ALT1); also known as glutamate-pyruvate transaminase 1. This enzyme catalyzes the reversible transamination between alanine and 2-oxoglutarate to generate pyruvate and glutamate and, therefore, plays a key role in the intermediary metabolism of glucose and amino acids. Serum activity levels of this enzyme are routinely used as a biomarker of liver injury caused by drug toxicity, infection, alcohol, and steatosis. A related gene on chromosome 16 encodes a putative mitochondrial alanine aminotransaminase
Share